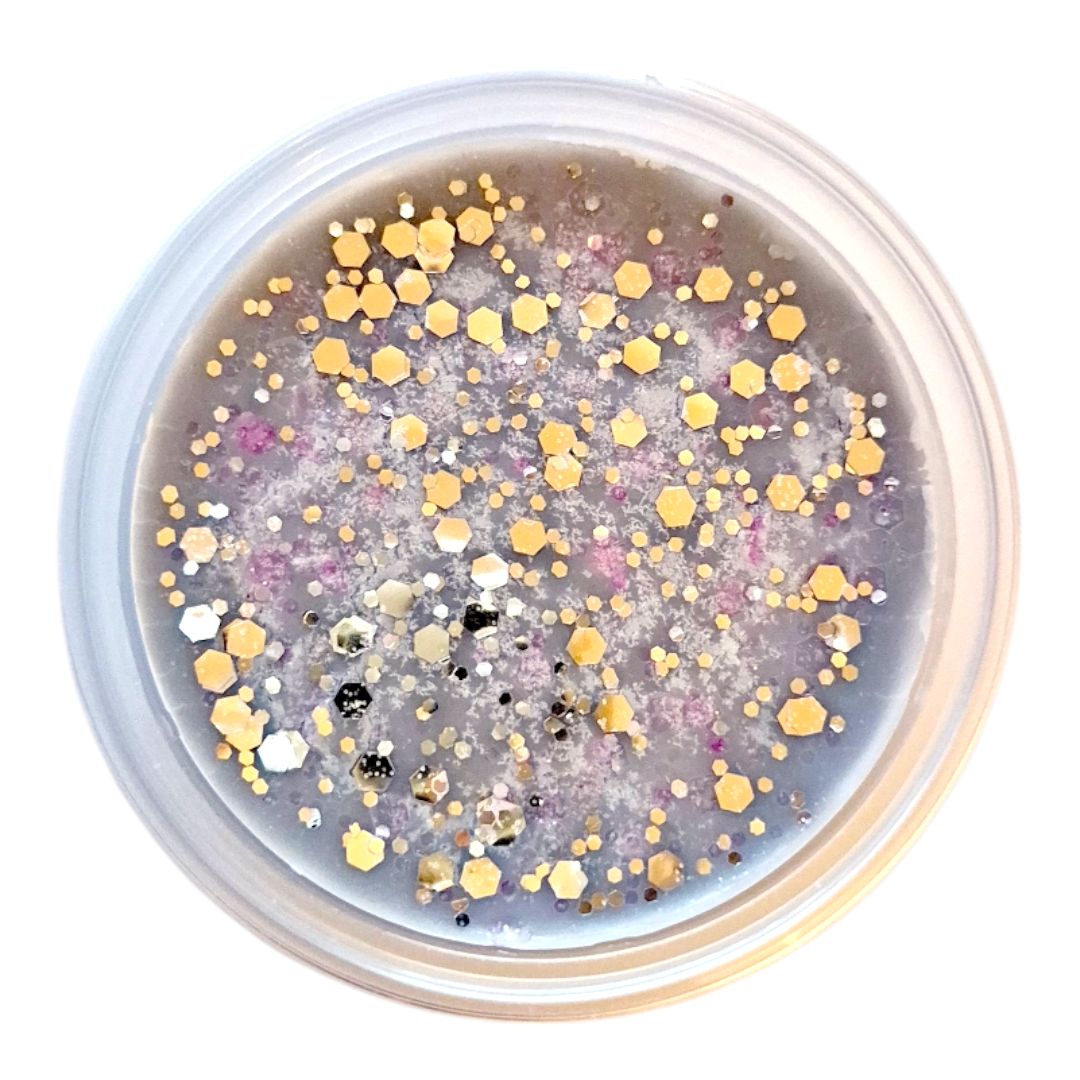

1
/
of
2
Sweater Weather - Wax Melt Pot
Sweater Weather - Wax Melt Pot
Regular price
£2.25
Regular price
£3.75
Sale price
£2.25
A sweet fruity accord opening with crisp apple, fresh citrus tones and breezy ozone leading to a heart of lily, jasmin and orchid on a base of autumn leaves, sugar and musk.
50g
Vegan and Cruelty Free
Quantity
Couldn't load pickup availability
Share
No reviews
Join Wax by Kaz!
Subscribe to our mailing list for insider news, product launches, and more.